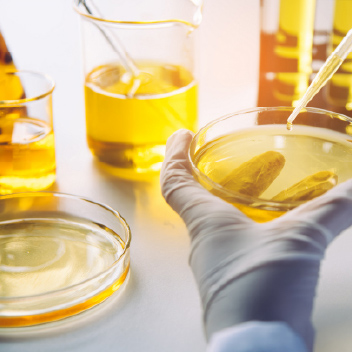
Cosmetic Raw Materials

About Us
BOC Sciences offers a wide range of daily chemical products, including daily chemical products, cosmetic ingredients, detergent ingredients and daily chemical additives, as well as a variety of testing services for daily chemicals to help our customers better develop their projects and accelerate their development process.
Learn More